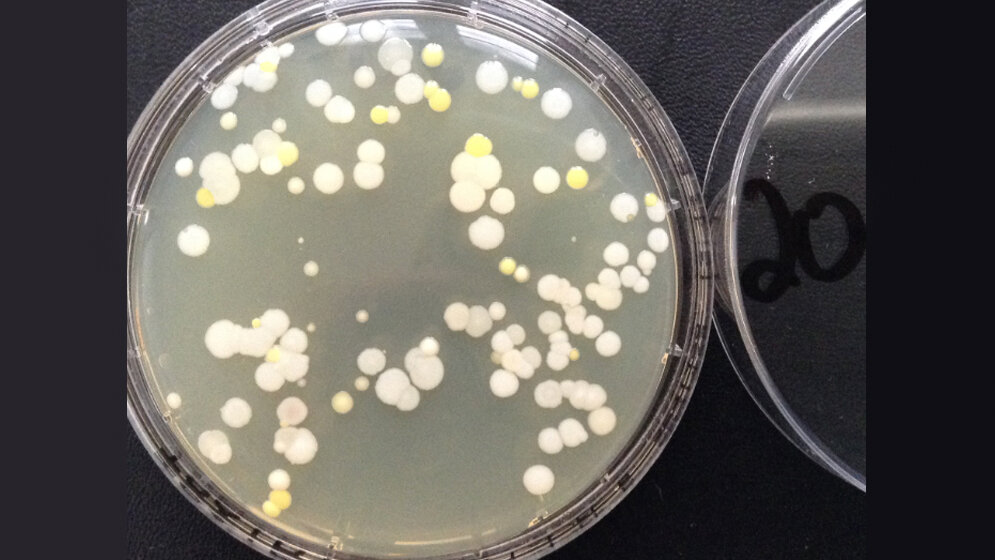
Hygieneprojekt Händehygiene

Bei der Überprüfung der Händedesinfektion ist der mikrobiologische Abdruck auf den ersten Blick eine objektive und kostengünstige Möglichkeit. Abdruckplatte auf die Hand gedrückt, nach zwei Tagen ein Ergebnis, Rückmeldung an die Betreffenden – fertig. In der Praxis ist die Thematik jedoch deutlich komplexer: Zunächst einmal die Tatsache, dass es im Rahmen der Befundbewertung keine Grenzwerte gibt – wie denn auch? Es wird üblicherweise nicht nur die frisch desinfizierte Hand beprobt, sondern es werden in unterschiedlichen Situationen unterschiedlich stark kontaminierte Hände untersucht. Somit fallen die Ergebnisse zwangsläufig sehr unterschiedlich aus. Ein anderer, nicht zu vernachlässigender Faktor ist die Sorge der Mitarbeiter: „Was passiert, wenn?“ Eine berechtigte Sorge. Man stelle sich vor, auf der Hand eines Mitarbeiters wird MRSA gefunden – was tun? (Anm.: Bei keiner Untersuchung wurden pathogene Erreger gefunden.) Dürfen die Hände von Mitarbeitern überhaupt untersucht werden, eventuell sogar gegen den Willen der Betroffenen, und welche Rolle übernimmt das Hygieneteam – Buhmann oder Motivator? Schon stehen wir mit unserer Idee der Handabdruckuntersuchungen in einem Minenfeld.
WIE IST DESINFEKTION DEFINIERT?
Zunächst aber die Frage: Wie ist Desinfektion definiert? Die Antwort finden wir bei der Kommission für Krankenhaushygiene und Infektionsprävention am Robert Koch-Institut (KRINKO): „Desinfektion ist ein Prozess ... mit dem Ziel, einen Gegenstand in einen Zustand zu versetzen, dass von ihm keine Infektionsgefährdung ausgehen kann“ (Anforderung an die Hygiene bei der Reinigung und Desinfektion von Flächen). Ein hoher Anspruch.
Ziel des St. Elisabeth Krankenhauses Köln-Hohenlind ist eine Verbesserung der Compliance der hygienischen Händedesinfektion. Dass Handabdruckuntersuchungen hierbei hilfreich sein können, steht für uns außer Frage. Aber wie kann man diese Kontrollmaßnahme so gestalten, dass sie als konstruktiv wahrgenommen wird?
Mit dieser Fragestellung haben wir ein Konzept entwickelt, welches seit 2016 zweimal jährlich umgesetzt wird:
1) Freiwilligkeit
Die Mitarbeiter werden gefragt, ob sie bereit sind, einen Abdruck der Hände vornehmen zu lassen. Wer nicht will, muss auch nicht. Dies ohne Bemerkung oder gar Vermerk an irgendeiner Stelle.
2) Anonymität
Bei der Durchführung wird die Abdruckplatte mit einer Nummer versehen, auf dem Begleitschein werden diese Nummer und (nur hier) der Name des Beprobten dokumentiert.
3) Erfassung der Arbeitssituation
Auf dem Begleitschein wird die Situation/Tätigkeit unmittelbar vor Probennahme dokumentiert.
4) Rückmeldung
Die Ergebnisse werden ausschließlich den Betroffenen, schriftlich, rückgemeldet. Hierzu wird die Abdruckplatte fotografiert, die Situation der Probennahme und das Ergebnis werden, ebenso wie eine kurze Bewertung, aufgeschrieben. Dieser Brief geht persönlich an die Betroffenen.
Ein persönliches Feedbackgespräch wäre zwar überaus wünschenswert, ist aber aus organisatorischen Gründen (unter anderem Zeit, Schichtdienst) leider nicht zu gewährleisten.
Erfahrungen
Die Probanden haben ein großes Interesse an den Ergebnissen, teilweise wurde bereits am nächsten Tag nach den Ergebnissen gefragt.
Werden die Briefe mit den Ergebnissen persönlich übergeben, gibt es offensichtlich keine Hemmungen, das Ergebnis zu kommunizieren. In der Regel werden die Kuverts sofort geöffnet, präsentiert und mit den Anwesenden diskutiert. Hat man das Glück und trifft mehrere Probanden an, werden die Ergebnisse miteinander verglichen. In Einzelfällen wurde um eine persönliche Erläuterung gebeten.
Fazit
Mikrobiologische Handabdruckuntersuchungen können eine konstruktive Maßnahme zur Verbesserung der Händehygiene sein. Voraussetzung ist eine transparente Vorgehensweise, eine individuelle Rückmeldung und ein vorwurfsloses Kommunizieren der Ergebnisse.
Im Bündel mit weiteren Maßnahmen wie Schulung, Spenderausstattung und Auswahl hautpflegender Präparate ist es möglich, die Compliance der Händehygiene zu verbessern.
Bei Durchsicht der Ergebnisse – im Sinne einer Evaluierung – fällt auf, dass die überwiegende Anzahl der Abdruckuntersuchungen bei Pflegepersonal durchgeführt wurde. Bei der Ärzteschaft herrscht noch eine gewisse Zurückhaltung bei der Annahme dieser Idee. Warum dies so ist, ist derzeit nicht nachvollziehbar.
* Hygienefachkraft, St. Elisabeth Krankenhaus Köln-Hohenlind, stefan.drees@hohenlind.de
Literatur
1. Anforderung an die Hygiene bei der Reinigung und Desinfektion von Flächen, Bundesgesundheitsbl – Gesundheitsforsch Gesundheitsschutz 2004 · 47: 51–61, DOI 10.1007/s00103-003-0752-9.
2. Händehygiene in Einrichtungen des Gesundheitswesens, Bundesgesundheitsbl 2016; 59: 1189–220, DOI 10.1007/s00103-016-2416-6.
3. Vereinigung der Hygienefachkräfte der Bundesrepublik Deutschland e.V. (VHD): Checkliste hygienerelevanter Umgebungsuntersuchungen, 4th revised edition 2019.
Entnommen aus MTA Dialog 9/2019
Artikel teilen